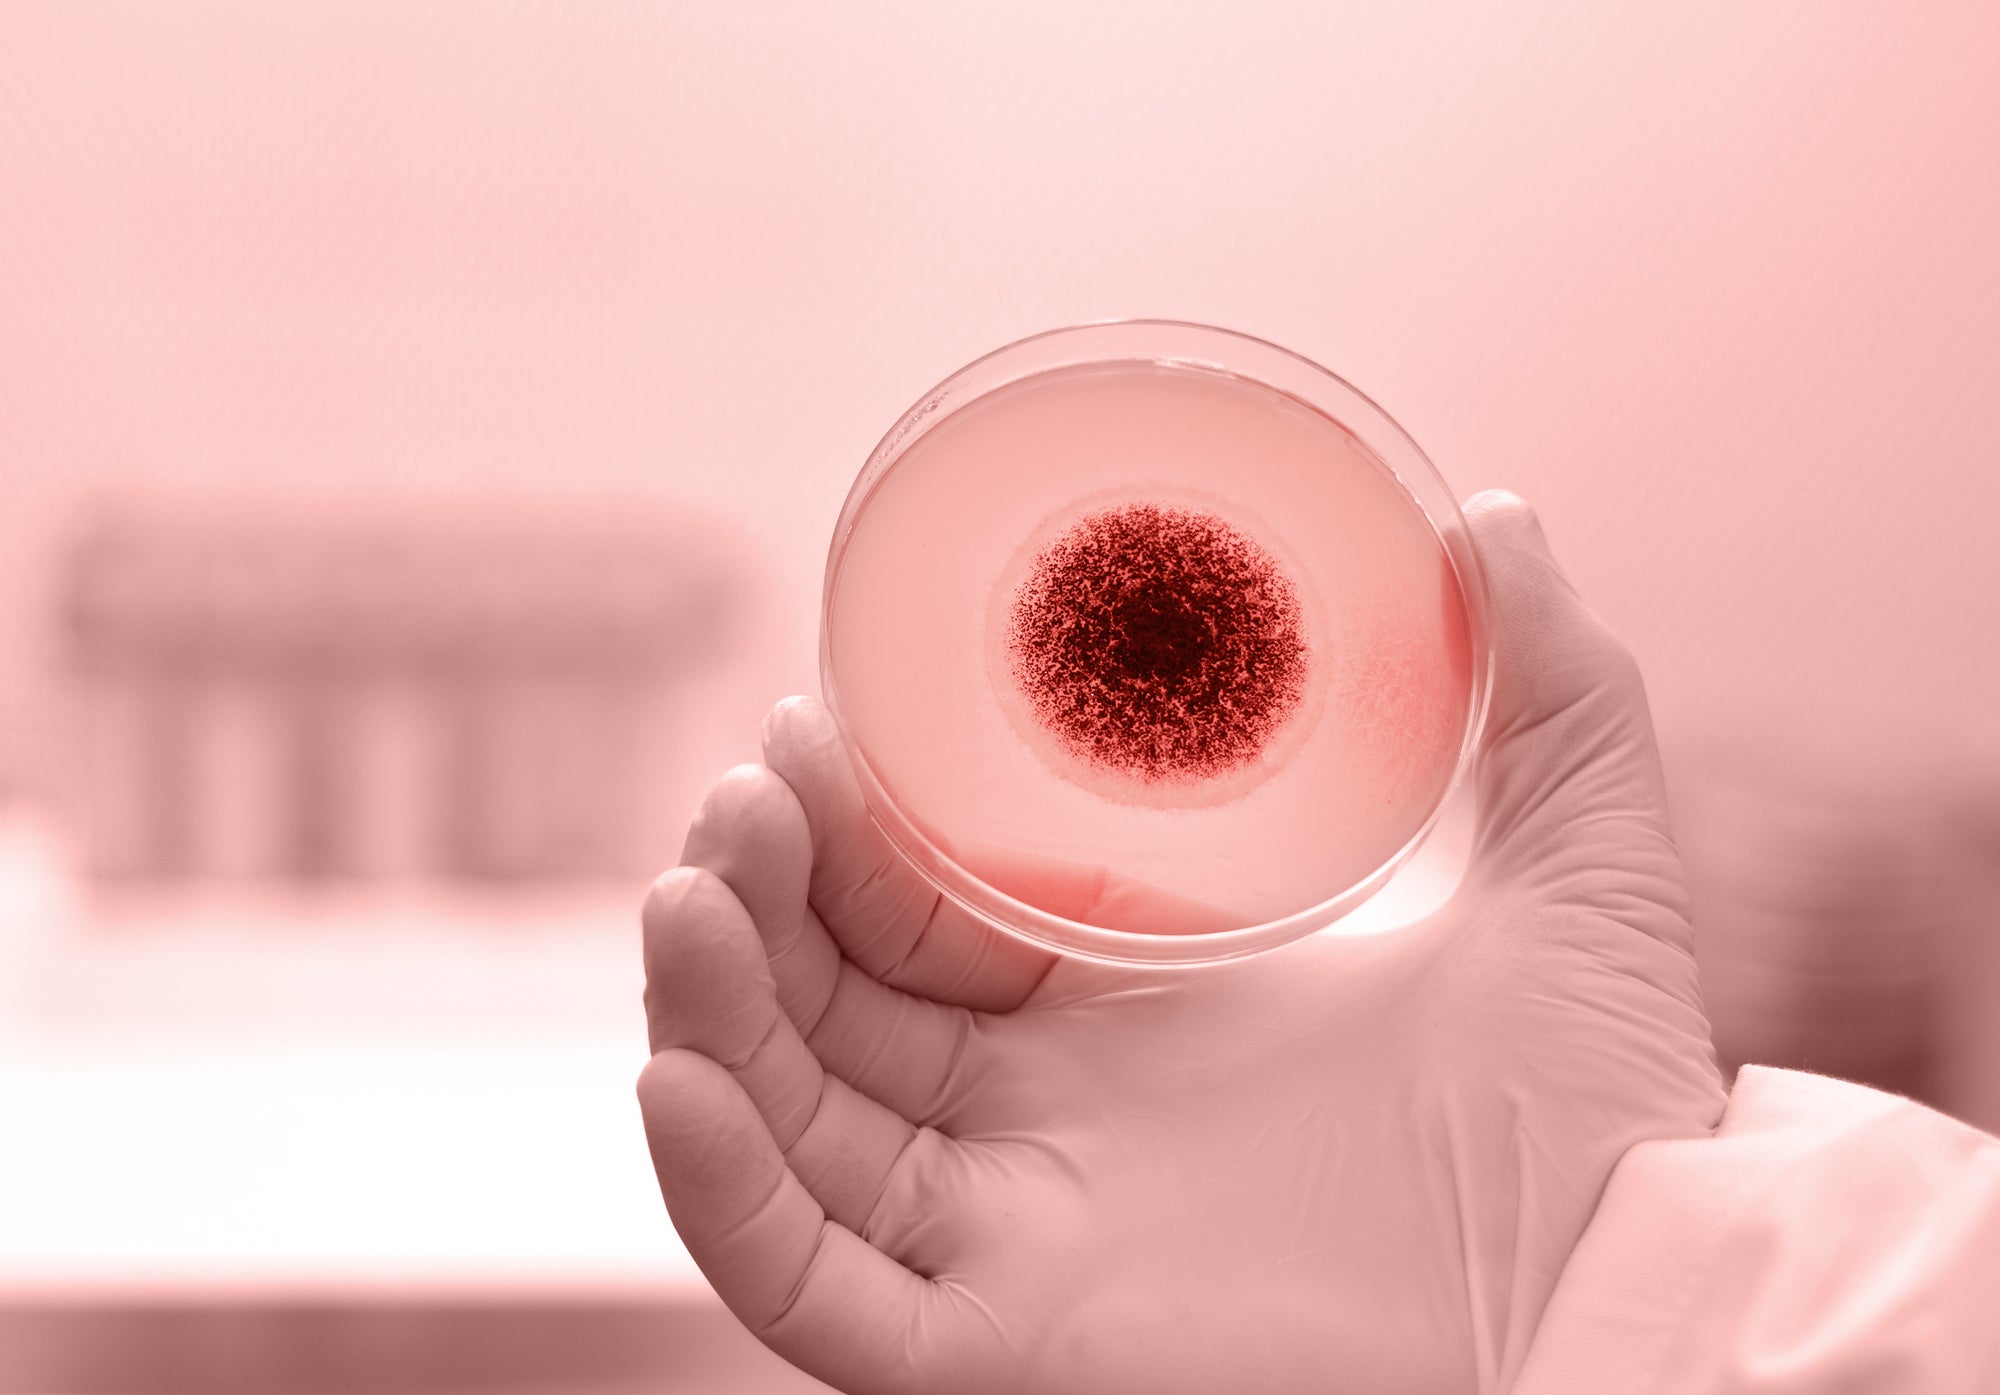

Keratin Feeds Tinea
Keratin’s Kryptonite: How Fungi Feed on Your Skin, Hair, and Nails
Dermatophytes, the fungi behind tinea infections, are not just passive invaders they are specialised predators of keratin, the protein that gives strength and structure to your skin, hair, and nails. These tinea spores have evolved unique strategies to break down keratin and thrive, turning your body into their personal buffet. Let’s explore how this process works and why fungal infections can be so hard to shake off.
Stop feeding the fungi. Take control with Real Good Honey’s natural, powerful solution that destroys tinea spores at the root.
What Is Keratin, and Why Do Tinea Spores Love It?
Keratin is a tough, fibrous protein found in the outermost layers of skin, hair, and nails. It acts as a barrier, protecting against environmental damage, water loss, and microbial invasion. Tinea spores have evolved to specialise in breaking down keratin because:
Keratin is everywhere on the human body, constantly replenished as skin, hair, and nails grow.
Its dense, fibrous composition provides tinea spores with a steady, durable food source.
Areas like feet, groins, and scalp create ideal conditions for tinea spores to thrive while feeding on keratin.
Tinea thrives on your keratin—but it doesn’t stand a chance against Real Good Honey. Start breaking the cycle today.

The Process of Fungal Colonisation
Tinea spores follow a systematic process to invade and colonise keratin-rich tissues:
Tinea spores land on keratin-rich areas of the body, such as feet or scalp. These spores adhere to the skin using specialised proteins, ensuring they stay in place even with movement or washing.
Once attached, tinea spores secrete keratinases, enzymes specifically designed to break down keratin. Imagine keratin as a locked treasure chest. Keratinases are the key that unlocks it, allowing the fungi to access the valuable nutrients inside.
The broken-down keratin is absorbed by the fungi as nutrients, fuelling their growth and reproduction. When you see discoloured or crumbling nails in a fungal nail infection, it’s a direct result of tinea spores digesting the keratin structure.
As the tinea spores consume keratin, they grow outward, colonising nearby skin, hair, or nails. For example, Athlete’s foot often starts between the toes but can spread to the soles or even the toenails if left untreated..
Tinea spores reproduce by creating more spores, which spread to other areas of the body or external surfaces, perpetuating the cycle.
Real Good Honey tackles spores at every stage, so you can heal naturally and effectively.

Why Fungal Infections Persist
Tinea spores follow a systematic process to invade and colonise keratin-rich tissues:
Tinea spores thrive because keratin is continuously replenished as part of the body’s natural growth cycle. Think of it like a self-refilling buffet—every time skin, hair, or nails regenerate, dermatophytes get fresh keratin to feed on.
Warm, moist areas like sweaty feet or poorly ventilated shoes provide the ideal breeding ground for fungi. Even after treatment, spores can remain dormant and reactivate when conditions improve.
The fungi stay in the outer layers of skin, where immune responses are weaker, allowing them to persist without much interference.
Real Good Honey targets spores where they live and thrive.

Breaking the Cycle with Real Good Honey
Real Good Honey’s hydrogen peroxide tinea honey is specifically designed to tackle tinea spores at their source—by destroying the resilient spores. Unlike traditional antifungal treatments that struggle to penetrate the spore’s tough exterior, this honey works in a unique, multi-faceted way:
The hydrogen peroxide in Real Good Honey penetrates the spore’s hard outer shell (cell wall), breaking down its structural integrity. This weakens the spore, making it unable to stay viable or reactivate under favourable conditions.
Once inside the spore, hydrogen peroxide and the honey’s bioactive compounds attack the internal structures, preventing the fungi from metabolising and feeding on keratin.
This two-pronged attack ensures the spore is fully destroyed, not just temporarily weakened.
Experience the natural power that fungi can’t resist.


How To Apply Real Good Honey
Mix 1 tsp of Jarrah TA35+ with 1 tsp of sorbolene cream until well combined. Apply the mixture onto the affected area. A minimum 2-hour treatment time is recommended but leaving on for longer is advantageous as the honey will continue to release hydrogen peroxide for up to 24 hours. Covering the treated area with clothing is optional (i.e. socks, gloves, clothing) is optional. Repeat daily for 14 days, or until symptoms have resolved. A maintenance application is recommended to reduce the risk of reinfection from infected sources and organic matter. If symptoms persist or worsen, consult your GP.